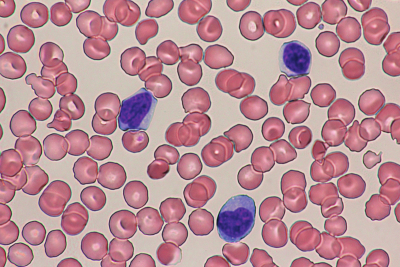
#

2歳の女児。発熱を主訴に母親に連れられて来院した。4日前から発熱があり、食欲が低下してきたため受診した。
体温38.8℃。眼瞼結膜と眼球結膜とに異常を認めない。咽頭に発赤を認める。両側の頸部に径1.5cmのリンパ節を数個触知する。心音と呼吸音とに異常を認めない。腹部は平坦、軟で、肝を右季肋下に2cm、脾を左季肋下に4cm触知する。
血液所見:赤血球425万、Hb 11.3g/dL、Ht 33%、白血球21,800(好中球20%、好酸球1%、好塩基球0%、単球5%、リンパ球74%、血小板19万。血液生化学所見:AST 78IU/L、ALT 66IU/L、LD 477IU/L(基準176~353)、尿酸4.7mg/dL。CRP 1.0mg/dL。胸部エックス線写真で心胸郭比50%。抹消血塗抹May-Giemsa染色標本を別に示す。
考えられる原因はどれか。2つ選べ。
a. EBウイルス感染症
b. パルボウイルスB19感染症
c. 単純ヘルペスウイルス感染症
d. サイトメガロウイルス感染症
e. ヒトT細胞白血病ウイルス感染症